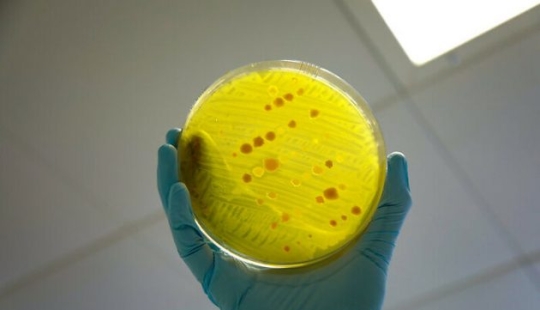
Hechos bastante inquietantes sobre el mundo.

Ciencias

16-12-2021
Respuestas a 9 preguntas históricas que aprendimos en 2021 ...
Quién, qué, cuándo, dónde y por qué: las cinco grandes preguntas. Cuando se trata de historia, las preguntas que entran en ...

13-12-2021
Los científicos dijeron qué tipo de sangre es "el más ...
¿Ha notado que algunas personas son picadas por mosquitos, mientras que otras prácticamente no lo son? ¿O tal vez eres la ...

11-12-2021
8 extrañas formaciones geológicas en la Tierra
¿Estás listo para ver algunas de las formaciones geológicas más geniales? El planeta Tierra está lleno de muchos accidentes ...

11-12-2021
9 hechos impactantes que pondrán tu mundo patas arriba
El mundo que nos rodea es asombroso y diverso. Y algunas cosas son tan obvias que nos sorprende sinceramente cuando nos enteramos ...

09-12-2021
10 descubrimientos científicos que suenan como ficción
Es hora de sentarse una vez más, doblar las manos, respirar hondo y mirar algunos de los titulares de artículos científicos a ...

09-12-2021
Cyborgs Vivos: Biohackers Ricos que quieren convertirse en ...
¿Te gustaría vivir para siempre? Criocámaras, inyecciones de células madre y transfusiones de "sangre joven": en el mundo de ...

08-12-2021
7 hechos sobre el cuerpo femenino que pocas personas conocen
Muchas personas conocen la increíble resistencia de los cuerpos femeninos y han escuchado algo sobre la diferencia entre el ...

02-12-2021
14 hechos sorprendentes y aterradores que la gente ha ...
La vida no se trata solo de animales lindos, obras de arte divertidas e historias útiles. Nuestro mundo está lleno de hechos ...

29-11-2021
Luna llena. El fotógrafo reúne 200.000 imágenes de la Luna ...
Las impresionantes imágenes nuevas ofrecen la vista más detallada de la superficie rugosa de la luna, revelando cada grieta con ...

27-11-2021
9 razones científicamente probadas para conseguir un perro
Leal, dispuesto a ayudar y siempre contento de verte-sí, él es, el mejor amigo del hombre! Los perros han estado acompañando a ...

26-11-2021
Dosis de esperanza: nuevas vacunas y medicamentos creados ...
Desde hace dos años, el mundo no ha sido capaz de salir de la trampa del coronavirus. Pero la covid no es el único problema que ...

25-11-2021
En los EE.UU., van a dar a los alcohólicos un trasplante de ...
Es difícil discutir el hecho de que el alcoholismo es una enfermedad terrible que destruye la salud, la personalidad y las ...

25-11-2021
10 respuestas a preguntas extrañas
¿Qué pasa si no te duchas ni hablas durante un año? ¿Y si la tierra deja de girar repentinamente? Por supuesto, a pocas ...

21-11-2021
10 alimentos y platos más mortíferos que debes evitar
Los diez alimentos más mortíferos para evitar

21-11-2021
Impresionantes fotos del astronauta francés de SpaceX ...
El astronauta Thomas Pesce acaba de terminar seis meses en la Estación Espacial Internacional en la misión SpaceX Crew-2 de la NASA.

19-11-2021
10 hechos inquietantes que probablemente no deberías haber ...
Por supuesto, podemos cerrar los ojos al lado oscuro del mundo. Pero no se pondrá más brillante. Incluso diríamos que, por el ...

18-11-2021
Insidiosa vitamina E: por qué un tratamiento prometedor para ...
Un descubrimiento inesperado mostró que los medicamentos con vitamina E, que muchas personas toman para la prevención del ...

17-11-2021
¿Necesitas aprender algo urgentemente? "Beber vodka!"- Dicen ...
Antes de leer este post, pondremos inmediatamente un claro descargo de responsabilidad: Los editores de Bigpikchi categóricamente ...

16-11-2021
6 peores trastornos del sueño
El sueño es una parte importante de nuestra vida. Nuestro cuerpo y cerebro descansan para ganar fuerza para el nuevo día. ...

06-11-2021
9 creaciones inventadas por mujeres que cambiaron el mundo ...
Las mujeres están acostumbradas a afrontar las penurias, con las que afrontan el mercado laboral y en la vida cotidiana en su ...

05-11-2021
Si los científicos fueran instagram
Imaginemos por un momento cómo diferentes científicos e ingenieros famosos podrían ejecutar redes sociales, en particular, un ...

02-11-2021
La princesa Diana entró en la familia Real de la amenaza de ...
Es sabido que el Reino — el lugar de nacimiento de muchos descubrimientos importantes en diferentes campos. No hace mucho ...

28-10-2021
12 hechos interesantes que han cambiado por completo nuestra ...
Durante las lecciones escolares, a menudo mirábamos por la ventana y no escuchábamos a los maestros que intentaban explicarnos ...

24-10-2021
7 consejos científicos para eliminar las arrugas
Por cierto, a medida que envejecemos, nos volvemos más sabios y experimentados. Las arrugas también aparecen con la edad, pero ...

22-10-2021
Frente a la costa de Israel, un buceador descubrió una ...
Según la Autoridad de Antigüedades de Israel, un buceador descubrió la espada en el fondo del Mar Mediterráneo en una bahía ...